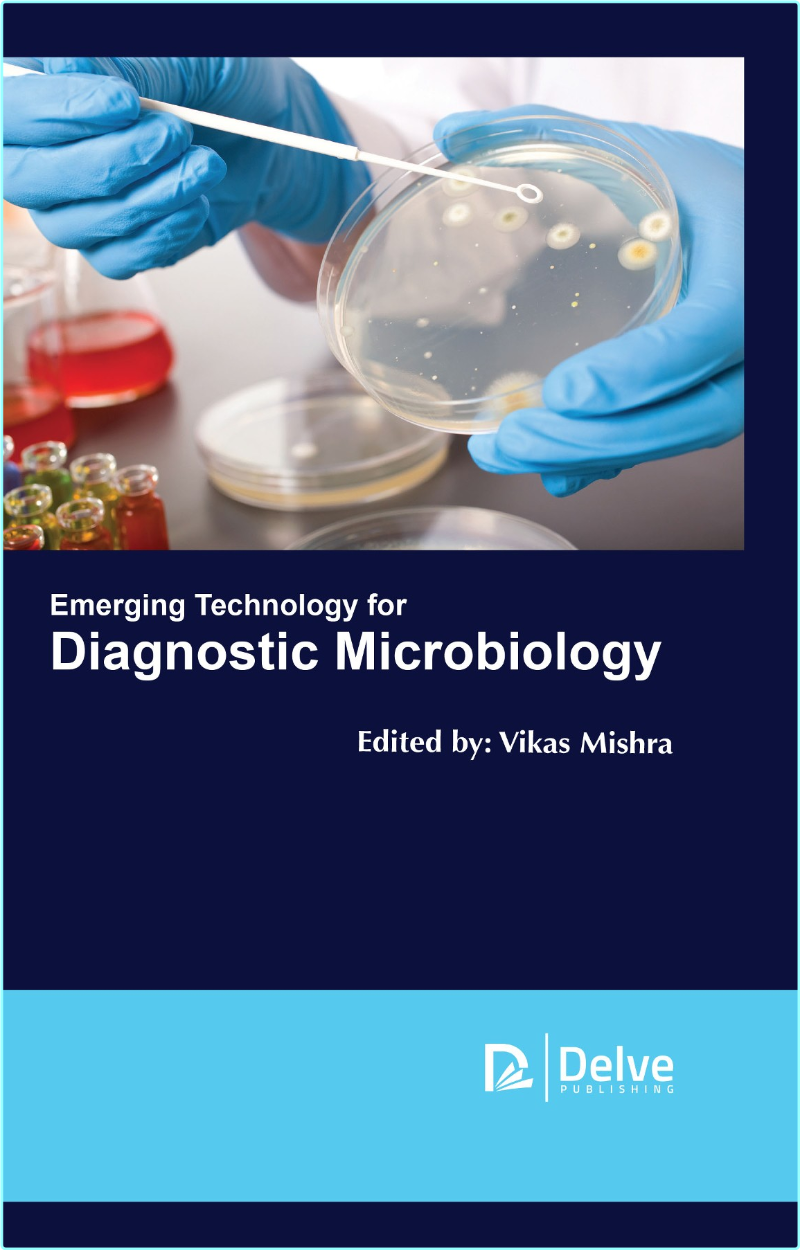
Emerging Technology For Diagnostic Microbiology (Vikas Mishra) Emerging Technology For Diagnostic Microbiology (Vikas Mishra)

English | ISBN: 1773615254 | 2019 | 496 pages | PDF | 60 MB 1773615254
Catergory: Science, Nonfiction
Emerging Technology for Diagnostic Microbiology examines various aspects of microbiology from fundamentals to advanced emerging technology. It includes definitions of PCR in diagnostic virology, technology in molecular detection and strain typing of microbes and microarray for diagnostic microbiology. Provides the reader with insights into the development of emerging technologies of diagnostics microbiology, so as to understand its application, innovation.
Contents of Download:
📌 1773615254.pdf (Vikas Mishra) (2018) (59.75 MB)
————————————*****————————————
⭐️ Emerging Technology For Diagnostic Microbiology ✅ (60.84 MB)
RapidGator Link(s)
https://rapidgator.net/file/8b71f540c5dd9c81ead87450744d2d77/Emerging.Technology.For.Diagnostic.Microbiology.rar
NitroFlare Link(s)
https://nitroflare.com/view/F587E350CDD8D4E/Emerging.Technology.For.Diagnostic.Microbiology.rar?referrer=1635666








